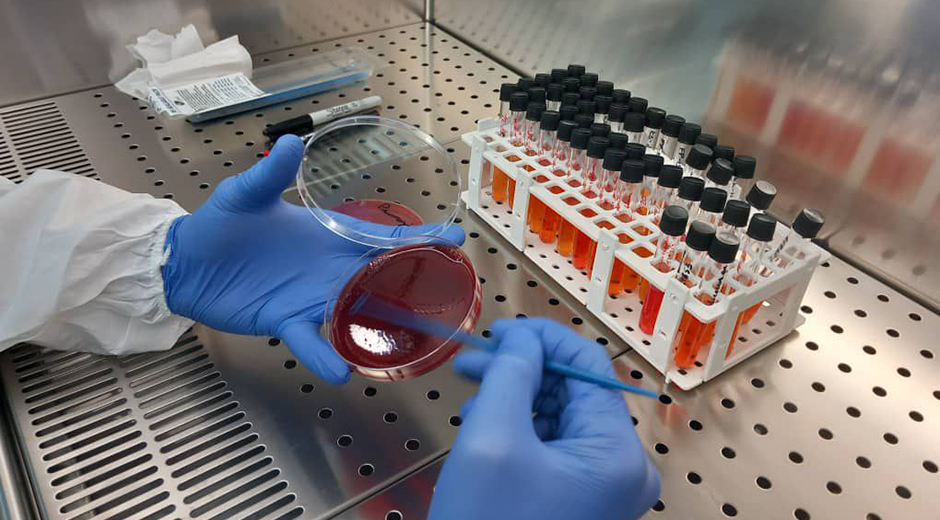

Grosso modo, la nanociencia abarca el estudio de fenómenos y la manipulación de materiales a nanoescala (un nanómetro es la millonésima parte de un milímetro o, para ilustrar con un ejemplo común: el grosor de un cabello humano es de entre 60 000 y 100 000 nanómetros).
La nanotecnología es la concreción de los resultados: el estudio, diseño, creación, manipulación o aplicación de materiales, dispositivos y sistemas funcionales con materia a nanoescala. Un ámbito muy lejano de la escala convencional que apreciamos y gestionamos en la cotidianidad y que, como otros de la ciencia avanzada, además de retar nuestra imaginación, está facilitando, acelerando saltos científicos y tecnológicos que configuran una revolución mundial y abriendo nuevos caminos.
En Cuba, con una Estrategia Nacional de Nanociencias y Nanotecnologías y un Programa Nacional de Nanociencias y Nanotecnologías desde 2018, fue inaugurado en 2019 el Centro de Estudios Avanzados (CEA), fruto de un proyecto que comenzó su camino en los primeros años de los 2000 y es parte del grupo empresarial BioCubaFarma.
Su director, el ingeniero Hugo Avilio Gutiérrez Ezcurra, comienza explicándonos que la plataforma experimental del centro está al servicio de la comunidad científica cubana y ha tenido mejoras progresivas en estos cinco años. Sus líneas de desarrollo abarcan los sectores de la bionanomedicina, la agricultura, la energía, el agua, el medioambiente, la construcción y la formación de recursos humanos.

Uno de los laboratorios del Centro de Estudios Avanzados, en La Habana. Foto: Cortesía CEA.
Técnicas en los servicios que brinda el CEA:
Microscopía de barrido de sonda con espectroscopía Raman
Microscopía de barrido de sonda
Microscopía confocal
Microscopía de fluorescencia
Microscopía electrónica de barrido
Espectrometría de fluorescencia de rayos X
Espectrometría de absorción atómica
Difractometría de rayos X
Calorimetría diferencial de barrido
Medición de tamaño de partículas (0.3 nm-300 µm)
Cromatografía líquida
Cromatografía líquida con espectrometría de masa
Análisis de carbono orgánico total
Espectrometría UV-VIS

El centro, luego de varias etapas, fue inaugurado en 2019 y los avances más importantes ocurrieron durante la pandemia de covid-19. Foto: Cortesía CEA.
Gutiérrez Ezcurra agrega que, no obstante, “el alcance de la nanociencia y la nanotecnología es muy amplio, por lo que participamos en proyectos sectoriales de otros sectores, como la industria ligera”.
Del CEA ya han salido aplicaciones prácticas y resultados diversos. Desde la etapa inversionista empezaron a generarse “los primeros resultados concretos, aun cuando se estaba trabajando en la formación del personal”, cuenta su director.
Pero los avances más importantes ocurrieron después del 2019, específicamente durante la pandemia de covid-19.
“Entre los resultados más relevantes estuvieron los protocolos en los centros de aislamiento, el sitio de toma de muestra que se iba a hacer, si era nasofaríngeo, si era faríngeo para la detección por PCR del virus. Todo eso el Minsap lo pudo optimizar y aplicar gracias a la primera investigación que se hizo en el CEA, acerca de la microscopía de alta resolución de SARS-CoV-2, donde se estableció cuáles eran las células que infectaba el virus, que había una prevalencia en la nasofaringe y no en la faringe. Esos resultados obtuvieron un premio de la Academia de Ciencias de Cuba.
“El segundo resultado muy importante fue el sistema de extracción cubana, con el cual hemos logrado una soberanía total para la extracción de ácidos nucleicos, un proceso clave en la realización de cualquier PCR diagnóstico, tanto para la parte forense y para enfermedades infecciosas como en estudios de cáncer. Este sistema de extracción nos da soberanía total en esa área.
“Estamos trabajando también en productos que van a tener un gran valor, como los destinados al control de determinadas infectaciones de importancia en la agricultura, y, en la salud pública, en la detección y resolución de los problemas de fertilidad en parejas que tratan de concebir hijos, o en la disminución de las ITS”.

La bionanomedicina es uno de los sectores que abarca el trabajo de los especialistas del CEA, además la agricultura, la energía, el agua, el medioambiente, la construcción y la formación de recursos humanos. Foto: Cortesía CEA.
El CEA desarrolla actualmente otros productos próximos a su registro. Entre ellos, el director del centro menciona los usados para la detección de resistencia antimicrobiana de una forma rápida y acelerada, “lo cual permite optimizar los tratamientos antimicrobianos. Permite al médico no solo definir qué antibióticos aplicar al paciente, sino en qué dosis, y confirmar si tienen resultados o no mediante biosensores que estamos desarrollando”.
En el CEA se obtuvo, en colaboración con el IPK y otras instituciones, el primer producto nanotecnológico con aplicaciones biomédicas creado ciento por ciento en Cuba mediante uso de nanopartículas magnéticas para extraer y concentrar el ARN del SARS-CoV-2 y confirmar con la prueba del PCR si hay contagio.
El diagnosticador, con el que se llegaron a realizar 20 000 determinaciones diarias en laboratorios de biología molecular de todo el país, recibió uno de los premios nacionales a la Innovación Tecnológica del Citma en 2021.
Cuando pregunto sobre la importancia de una institución como el CEA en el contexto de Cuba y cuánto puede aportar, el director del centro responde que es estratégico para el desarrollo científico nacional y destaca su concepción como “plataforma abierta multidisciplinaria con tecnología de punta, en algunos casos tecnología que, por sus prestaciones, es única en el país, y laboratorios con potencialidades para desarrollar investigaciones que antiguamente requerían salir al extranjero por largos periodos de tiempo y que hoy podemos hacer en Cuba”.
La visión del CEA −añade− va más allá del desarrollo de las nanociencias y las nanotecnologías, tiene una relevancia a nivel de país para el desarrollo de las ciencias en general en Cuba.
“Estamos hablando de la biotecnología, de las ciencias de la vida, las ciencias de la salud, las ciencias de los materiales… Porque el CEA es una plataforma o un conjunto de instalaciones con equipamiento y personal altamente calificado, con un experiencia y conocimiento que hemos logrado agrupar en un solo centro; con condiciones de laboratorio y experticias que normalmente en el mundo se encuentran diseminadas”, dice.
Foto: Cortesía CEA.
Hoy, la nanociencia y las nanotecnologías son el centro de una revolución tecnológica de escala mundial. Gutiérrez Ezcurra menciona como ejemplo el procesador cuántico experimental Willow, presentado en diciembre último por Google, el más reciente hito en el campo de la computación cuántica, que persigue aplicar los principios de la física de partículas para lograr computadoras mucho más poderosas que las actuales.
“Eso se ha podido lograr gracias al uso de nanomateriales y a los nanochips. El avance de la nanociencia y las nanotecnologías en el mundo está permitiendo el desarrollo también en campos como la inteligencia artificial y la medicina. Con el uso de nanotecnologías se están resolviendo problemas tecnológicos muy complejos de una forma muy sencilla”, comenta.
“Cuba no es ajena a ese contexto. No es que estemos en una ciencia de frontera y a la vanguardia de esas investigaciones, pero sí es relevante en nuestras realidades y en las líneas tecnológicas que estamos trabajando para resolver con nanotecnología algunos de los problemas que enfrentamos. No todos los problemas se pueden afrontar de la misma forma, no todos tienen solución con nanotecnología, pero otros muchos sí”, sostiene el director del CEA.
Explica que consolidar el desarrollo de la nanociencia y las nanotecnologías en Cuba “permite, en primer lugar, actualizar procedimientos, tecnologías, productos y servicios que han quedado obsoletos en determinados ámbitos”.
En el caso de productos que se comercializan, “al enfocarlos desde una visión de la nanociencia y las nanotecnologías podemos aumentar su valor agregado, mejorar su desempeño y ser competitivos a nivel internacional”.
En cuanto al marco regulatorio, señala que se ha aprobado un conjunto de normas que rigen el desarrollo de los nanoproductos y las nanotecnologías en Cuba.
“Como parte del Programa Nacional de Nanociencias y Nanotecnología del Citma, estamos en un proceso de formación de investigadores con cursos, seminarios, talleres acerca de las normas, los instrumentos regulatorios a nivel internacional sobre nanociencia y nanotecnología, porque cada día es algo más cotidiano. No podemos alejarnos de los marcos regulatorios internacionales, dominarlos es fundamental para tener un mercado tecnológico competitivo”, dice Gutiérrez Ezcurra.

Centro de Estudios Avanzados (CEA), en La Habana. Foto: Cortesía CEA.
Actualmente, el CEA cuenta con una plantilla de 63 personas (38 de ellas dedicadas a la actividad fundamental, I+D+I) e incluye a cinco doctores en Ciencias, ocho másteres y 24 ingenieros en ramas como biología, bioquímica, física teórica, física nuclear, radioquímica, microbiología, química y automática.
El CEA −destaca su director− “es un centro joven, formado por jóvenes, que ha tenido un devenir después de su inauguración. Como mismo hemos crecido en resultados científicos y en el saber hacer, también hemos crecido en la formación de recursos humanos, algo a lo que dedicamos mucho, mucho tiempo. No estamos ajenos al contexto nacional, sufrimos el éxodo de personal calificado y tenemos los mismos problemas que están enfrentando la sociedad cubana y otros centros de la ciencia en Cuba.
“Hasta ahora, hemos tratado de consolidar un equipo unido. Somos pocos, hemos consolidado un saber hacer y una experticia en cada uno de los campos en que nos estamos desarrollando y cada día tratamos de unirnos más como colectivo de equipo”.

El CEA, destaca su director, es un centro joven, formado por jóvenes. Ha crecido en resultados científicos, en el saber hacer y en la formación de recursos humanos. Foto: Cortesía CEA.
Entre los retos, menciona los de una realidad compleja que también alcanzan a una institución “que es única en Cuba, estratégica para el desarrollo del país, a veces no valorada en su justa medida y en su justa importancia por algunos.
“Realmente es una institución estratégica. El día que se logre comprender este hecho, que fue la visión de quienes fundaron el CEA y el proyecto CEA, se entenderá que tenemos algo que no es común en el mundo: una fortaleza para el país. No todos los países tienen una institución o un programa nacional de nanociencia y nanotecnología que aglutine tanto el desarrollo de las ciencias y las tecnologías.
“¿Barreras a superar? Tenemos barreras, por supuesto. Barreras económicas que frenan un poco el desarrollo, las dinámicas de la demografía, en ocasiones la falta de motivación de profesionales a venir al CEA, pero hay una que puede afectar mucho: la subvaloración de esta institución y de su quehacer en el contexto nacional. El principal reto a superar es darle mayor visibilidad y lograr que personas en otros campos y decisores otorguen al CEA y a su trabajo la importancia que merece en el contexto cubano de hoy”.

Foto: Cortesía CEA.
Entre los proyectos del CEA con resultados están:
- Desarrollo de nanopartículas fluorescentes para aplicaciones biológicas
- Desarrollo de una plataforma nanotecnológica para la formulación de inmunógenos basados en ácidos nucleicos
- Obtención de sensores de micropresión impulsados por nanoarquitecturas
- Manual práctico para integrar la gestión de los riesgos derivados del uso de nanomateriales en las entidades cubanas
- Soluciones nanotecnológicas para el fortalecimiento del monitoreo de la calidad del agua
- Diseño de biosensores nanotecnológicos para la detección de resistencia antimicrobiana
- Diseño de una plataforma para diagnosticadores inmunocromatográficos basados en nanopartículas fluorescentes
En esos proyectos han participado, además, instituciones como el Instituto de Medicina Tropical Pedro Kourí (IPK), Instituto de Ciencia y Tecnología de Materiales (IMRE) de la UH, Instituto Superior de Tecnologías y Ciencias Aplicadas (Instec), Centro de Biomateriales (Biomat) de la UH, Instituto Cubano de Investigaciones de los Derivados de la Caña de Azúcar (Icidca), Instituto Nacional de Salud de los Trabajadores (Insat), Instituto Nacional de Recursos Hidráulicos (INRH), Empresa de Investigaciones y Proyectos Hidráulicos de La Habana (EIPHH) y Empresa Nacional de Análisis y Servicios Técnicos (Enast) de Camagüey.

Foto: Cortesía CEA.

Foto: Cortesía CEA.

Foto: Cortesía CEA.

Foto: Cortesía CEA.
Tomado de Cubadebate